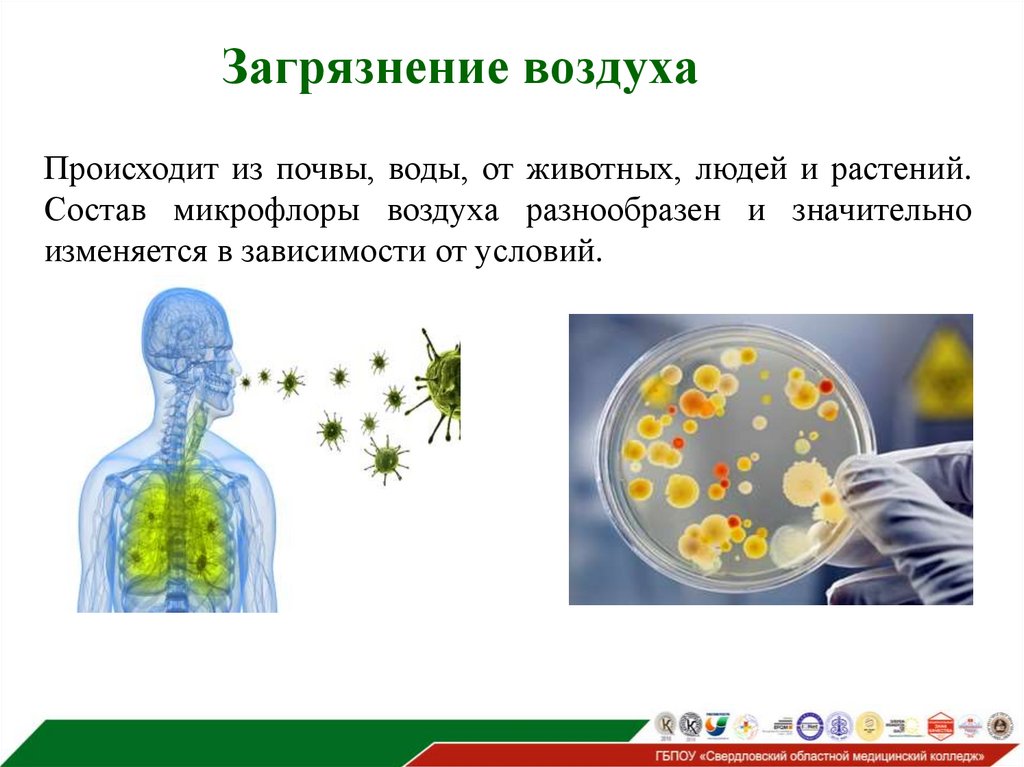
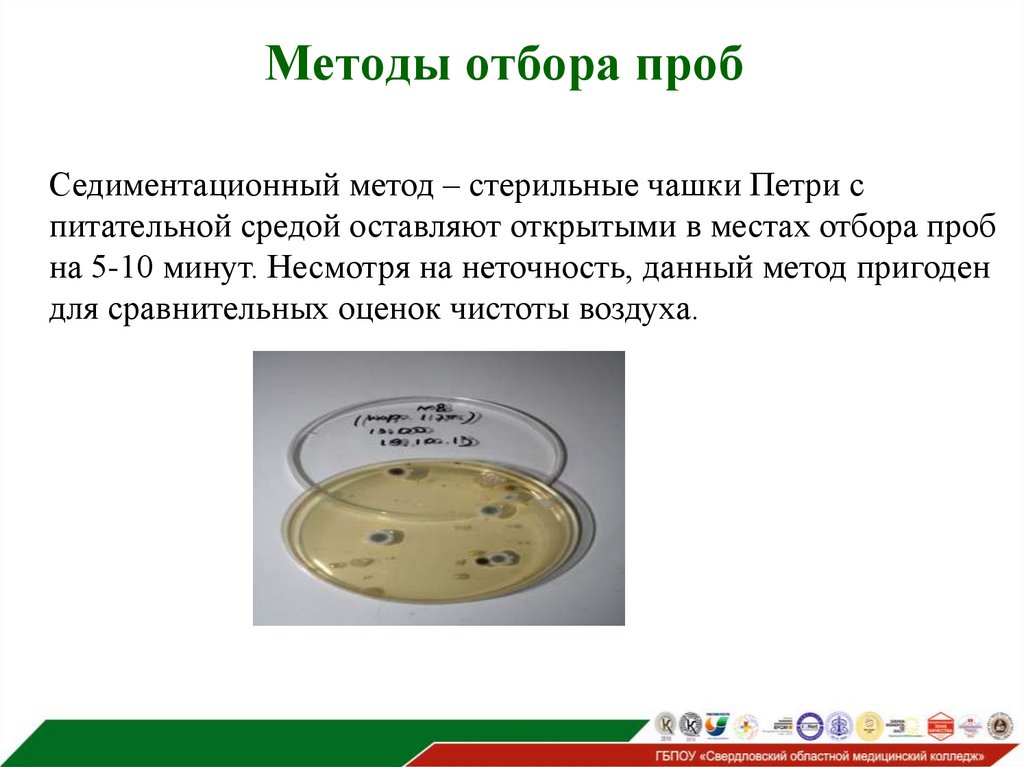

Similar presentations:
Роль медицинского лабораторного техника при проведении санитарно-бактериологического исследования воздуха в закрытых помещениях
1.
МИНИСТЕРСТВО ЗДРАВООХРАНЕНИЯ СВЕРДЛОВСКОЙ ОБЛАСТИРоль медицинского лабораторного техника при
проведении санитарно-бактериологического
исследования воздуха в закрытых помещениях
Выпускная квалификационная работа
Исполнитель: Иванова Анастасия Николаевна
студентка группы 301
специальность: Лабораторная диагностика.
Руководитель: Матвейчева Светлана
Владимировна
Екатеринбург
2025
2. Актуальность исследования
Актуальность санитарно-микробиологического исследованиявоздуха в больницах обусловлена тем, что микробное
распространение и накопление в больничной среде способно
привести к инфицированию пациентов и персонала,
развитию и распространению инфекций при оказании
медицинских услуг. Задачами такого исследования являются
гигиеническая и эпидемиологическая оценка воздушной
среды и, как следствие, разработка комплекса мероприятий,
направленных на профилактику аэрогенной передачи
возбудителей инфекционных болезней.
3. Цель и задачи исследования
Цель: изучить роль медицинского лабораторного техникав санитарно-бактериологическом исследовании воздуха
Задачи исследования:
1. Показать значимость роли медицинского лабораторного
техника при санитарно-бактериологическом исследовании
воздуха.
2. Изучить преаналитический этап, способы и методы
отбора проб.
3. Провести исследование и проанализировать результаты
санитарно-бактериологического исследования проб воздуха,
взятых в период апрель-май 2025 года.
4. Объект исследования
Деятельность медицинских лабораторных техников припроведении санитарно-бактериологического исследования
воздуха.
Предмет исследования
Санитарно-показательные микроорганизмы воздуха.
5.
Воздух – среда, неподдерживающая
размножение
микроорганизмов, это
определяется отсутствием
питательных веществ и
недостатком влаги.
6. Микробиота воздуха
Выделяют несколько групп микроорганизмов, обнаружение которых вобъектах окружающей среды говорит о различных видах загрязнения:
• группа А включает в себя обитателей кишечника человека и
животных (БГКБ).
• группа В включает в себя обитателей верхних дыхательных путей и
носоглотки (стафилококки, зеленящие и гемолитические
стрептококки).
• группа С включает микроорганизмы-сапрофиты, обитающие во
внешней среде (аммонифицирующие, нитрифицирующие бактерии).
7. Загрязнение воздуха
Происходит из почвы, воды, от животных, людей и растений.Состав микрофлоры воздуха разнообразен и значительно
изменяется в зависимости от условий.
8. Санитарно-показательные микроорганизмы воздуха
Это микроорганизмы, обитающие в кишечнике или в верхнемотделе дыхательных путей человека и животных, постоянно
выделяющиеся в окружающую среду.
Золотистый стафилококк
Дрожжи
Стрептококки
9. Механизм попадания патогенных микроорганизмов в воздух
Патогенные микроорганизмы попадают в воздух с мокротой ислюной при кашле, чихании и разговоре. Здоровый человек при
каждом акте чиханья выделяет в воздух 10000-20000 микробных
тел, а больной во много раз больше.
10. Механизм попадания патогенных микроорганизмов в воздух
Мельчайшие капельки могут часами удерживаться в воздухе вовзвешенном состоянии, образуя стойкие аэрозоли. В этих
капельках, за счет влаги, микроорганизмы выживают дольше.
Таким воздушно-капельным путем происходит заражение
многими острыми респираторными заболеваниями, в том числе
гриппом, корью, коклюшем, туберкулезом и т.д.
11. Распространение патогенных микробов через воздух
Мельчайшие капельки могут часами удерживаться в воздухе вовзвешенном состоянии, образуя стойкие аэрозоли. В этих
капельках, за счет влаги, микроорганизмы выживают дольше.
Таким воздушно-капельным путем происходит заражение
многими острыми респираторными заболеваниями, в том числе
гриппом, корью, коклюшем, туберкулезом и т.д.
12. Распространение патогенных микробов через воздух
Помимо капельного способа, распространение патогенныхмикробов через воздух может осуществляться пылевым путем.
Пылевой путь играет особенно важную роль в эпидемиологии
туберкулеза, дифтерии, туляремии и других заболеваний.
13. Санитарно-бактериологическое исследование воздуха
Начинается с отбора проб. Способы отбора проб:Пробы берут на уровне сидящего или стоящего человека,
выделяя одну точку взятия проб на каждые 20м2.
По типу конверта: 4 точки находятся по углам помещения, а
пятая в центре.
Следует брать пробы на расстоянии 1,6м от поверхности пола.
Процедура проводится в дневное время, когда у людей
наблюдается наибольшая активность.
14. Методы отбора проб
Седиментационный метод – стерильные чашки Петри спитательной средой оставляют открытыми в местах отбора проб
на 5-10 минут. Несмотря на неточность, данный метод пригоден
для сравнительных оценок чистоты воздуха.
15. Методы отбора проб
Аспирационный метод-является более точным. Пробыотбираются с помощью специальных аспираторов, через который
засасывается определенный объем воздуха. Для взятия проб
применяются различные приборы, ПОВ-1, БВЭП-1 И ПУ-1Б
(последний является рекомендованным для обора проб в
помещениях).
ПОВ-1
БВЭП-1
ПУ-1Б
16. Аспирационный метод
Для определения количества золотистого стафилококка черезаспиратор засасывают 250 литров воздуха, проводя посевы на
кровяной агар. После транспортировки проб, аналитического
этапа проводят подсчет общего микробного числа, а также
бактериологическое исследование на стафилококк.
17. Общее количество проб за 2024 и 2025 год
18. Количество проб не в норме за 2024 год
19. Количество проб не в норме за 2025 год
20.
МИНИСТЕРСТВО ЗДРАВООХРАНЕНИЯ СВЕРДЛОВСКОЙ ОБЛАСТИРоль медицинского лабораторного техника при
проведении санитарно-бактериологического
исследования воздуха в закрытых помещениях
Выпускная квалификационная работа
Исполнитель: Иванова Анастасия
Николаевна
студентка группы 301
специальность Лабораторная диагностика.
Руководитель: Матвейчева Светлана
Владимировна
Екатеринбург
2025

biology
biology








